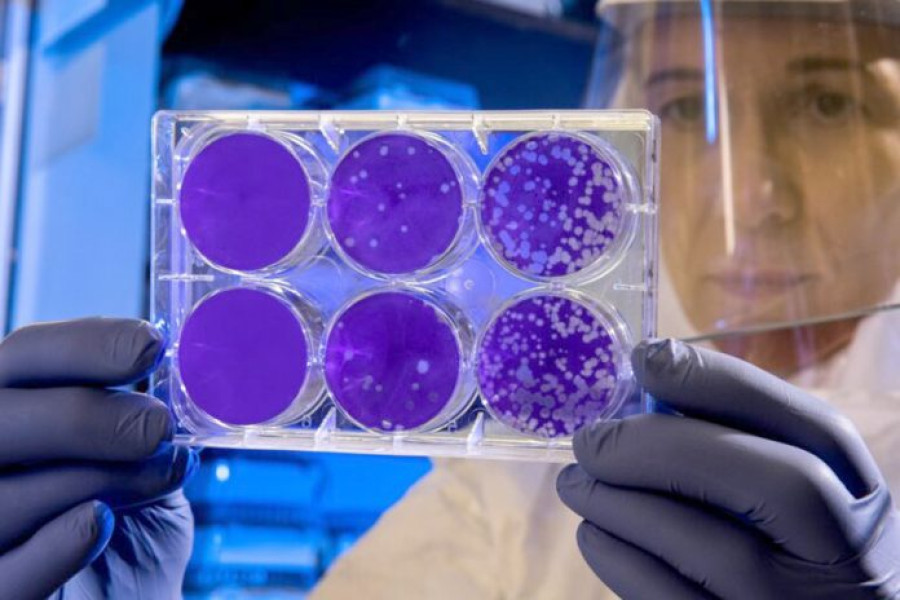

Antibioticul sintetic Novltex eficient împotriva bacteriilor rezistente multiple
Update cu 2 săptămâni în urmă
Timp de citire: 1 minut
Articol scris de: Andrei Miroslavescu
Antibioticul sintetic Novltex eficient împotriva bacteriilor rezistente multiple
Un nou antibiotic sintetic, denumit Novltex, a arătat în laborator o eficienţă remarcabilă în combaterea unor bacterii rezistente la diverse medicamente. Printre acestea se află patogeni incluși pe lista priorităților stabilită de Organizația Mondială a Sănătății (OMS).
Testele de laborator au relevat că Novltex depășește în eficiență antibiotice deja aprobate și uzuale, cum sunt vancomicina, daptomicina, linezolidul, levofloxacina și cefotaximul. Această performanță indică un potențial ridicat al noului tratament în fața infecțiilor dificile.
Conform ziarulprahova.ro, studiul publicat în Journal of Medicinal Chemistry relevă că Novltex a reușit să elimine tulpini periculoase, inclusiv Staphylococcus aureus rezistent la meticilină (MRSA), utilizând doze extrem de mici. Această descoperire reprezintă un progres important în lupta cu bacteriile rezistente.
Rezultatele cercetării pun bazele unor noi opțiuni terapeutice împotriva agenților patogeni care au devenit o provocare serioasă pentru tratamentele convenționale, fiind astfel esențială continuarea studiilor pentru utilizarea clinică a Novltex.